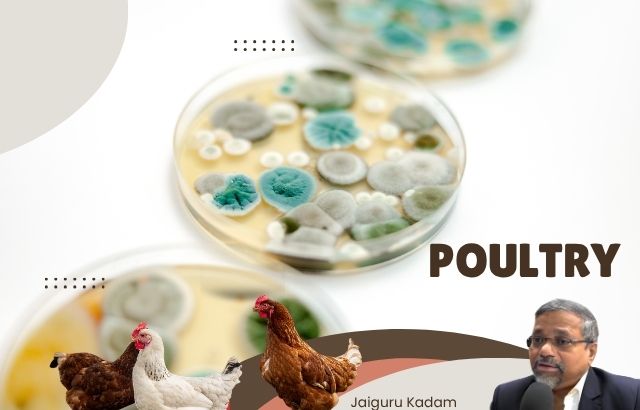

As the demand for sustainable and high-quality poultry products continues to rise, more poultry farmers are turning to green innovations to improve the health and productivity of their flocks. One such innovation is the use of probiotics — live microorganisms that confer health benefits when administered in adequate amounts. Probiotics not only support gut health but also enhance immunity, improve feed efficiency, and ultimately contribute to better poultry meat and egg quality.
In this blog post, we will dive into the top probiotic strains commonly used in poultry farming, their specific benefits, and how these strains can lead to healthier birds and more sustainable poultry production. Additionally, we will draw on the expert insights of Jaiguru Kadam, a leader in green innovation for agriculture, to provide real-world examples of how probiotics can transform poultry farming.
The Role of Probiotics in Poultry Farming
Before we explore specific probiotic strains, it’s essential to understand why probiotics are crucial for poultry health. Poultry, like all animals, have a delicate balance of gut microbiota that plays a vital role in digestion, immune function, and overall well-being. When the balance of this microbiota is disrupted, birds become more susceptible to diseases, digestive issues, and poor growth rates.
Probiotics help restore this balance by promoting the growth of beneficial bacteria in the gut, which in turn supports digestion, nutrient absorption, and immune system function. In poultry, the use of probiotics has been linked to:
- Improved gut health and digestion
- Increased feed conversion efficiency, which reduces feed costs
- Enhanced immunity leading to healthier birds
- Better meat quality and improved egg production quality
Jaiguru Kadam, an expert in sustainable poultry practices, has witnessed firsthand how probiotics can transform a poultry farm, not just by improving productivity but also by fostering a more natural, environmentally friendly approach to farming.
Commonly Used Probiotic Strains in Poultry
Different strains of probiotics have varying effects on poultry health. Below are the top probiotic strains commonly used in poultry farming and their specific benefits:
1. Lactobacillus spp. (Lactobacillus acidophilus)
Lactobacillus is one of the most widely used probiotic strains in poultry farming. Known for its ability to acidify the gut, Lactobacillus helps in the suppression of harmful pathogens like Salmonella and E. coli, which can cause severe infections in poultry.
- Benefits:
- Enhances gut health by maintaining a low pH environment that inhibits pathogenic bacteria.
- Boosts immunity, improving the birds’ resistance to infections.
- Improves feed conversion rates, leading to better growth and efficiency.
Jaiguru Kadam’s Insight: “In my experience, incorporating Lactobacillus acidophilus into poultry diets has consistently resulted in improved growth rates and fewer incidences of gastrointestinal disorders, which are common in intensive farming systems.”
2. Bifidobacterium spp.
Bifidobacterium is another powerful probiotic that supports the gut microbiome by outcompeting harmful bacteria. It also promotes the production of short-chain fatty acids (SCFAs), which are essential for gut health and overall immunity.
- Benefits:
- Enhances gut health and aids in the breakdown of fiber, improving digestion.
- Supports immune function by stimulating the production of antibodies.
- Reduces harmful pathogens and improves feed intake.
Jaiguru Kadam’s Insight: “We’ve seen Bifidobacterium strains deliver notable improvements in immunity and overall gut health. By reducing harmful bacteria and increasing the absorption of nutrients, this probiotic has contributed to better quality eggs and healthier, more robust birds.”
3. Enterococcus faecium
Enterococcus faecium is a well-known probiotic strain for poultry farming. This strain is particularly effective in promoting intestinal health and preventing diseases caused by Clostridium and Salmonella.
- Benefits:
- Promotes intestinal health and prevents digestive upsets.
- Reduces pathogen colonization by outcompeting harmful bacteria.
- Improves nutrient absorption, leading to better overall bird health.
Jaiguru Kadam’s Insight: “In my consultations with poultry farmers, Enterococcus faecium has consistently proven effective in reducing the incidence of digestive disorders and enhancing overall bird performance. We’ve seen birds grow faster, with healthier plumage and a significant reduction in the use of antibiotics.”
4. Saccharomyces cerevisiae (Yeast)
While not a bacteria, Saccharomyces cerevisiae (a type of yeast) is frequently included in probiotic blends for poultry. This yeast strain is a natural prebiotic that promotes the growth of beneficial bacteria and boosts immune response.
- Benefits:
- Improves feed conversion efficiency.
- Promotes digestion by increasing the absorption of nutrients.
- Stimulates immune response, enhancing disease resistance.
- Supports gut flora balance.
Jaiguru Kadam’s Insight: “Incorporating Saccharomyces cerevisiae has been a game changer for farms focused on organic and antibiotic-free production. The added benefits of improved feed conversion and immune response make it an excellent option for small to medium-scale farmers looking for a sustainable edge.”
5. Bacillus subtilis
Bacillus subtilis is a spore-forming bacterium known for its antibacterial properties and its ability to survive harsh conditions in the gut. This strain is especially helpful in preventing gastrointestinal infections and promoting a healthy intestinal environment.
- Benefits:
- Enhances gut immunity and reduces the risk of gut-related diseases.
- Inhibits harmful bacteria, leading to better overall health.
- Improves digestibility of feed, increasing growth rates and efficiency.
Jaiguru Kadam’s Insight: “What sets Bacillus subtilis apart is its ability to survive in both the feed and the digestive system. We’ve seen remarkable results in terms of both growth performance and disease prevention, particularly in environments where biosecurity is difficult to maintain.”
Practical Examples: Jaiguru Kadam’s Probiotic Solutions for Poultry Farms

Jaiguru Kadam’s work in poultry farming has shown how these probiotic strains can significantly improve farm productivity. His recommendations have helped numerous farms increase both meat quality and egg production, reduce disease incidence, and maintain sustainable practices.
Example 1: Boosting Egg Production with Probiotics
In a recent project, Jaiguru worked with a large egg production farm that was struggling with fluctuating egg production. After introducing a Lactobacillus and Bifidobacterium blend into the hens’ diet, egg production increased by 12% over three months. The eggs were also found to have richer yolk color and improved nutritional profiles, which led to higher market demand.
Example 2: Reducing Antibiotic Use with Bacillus subtilis
Jaiguru collaborated with a poultry farm that was aiming to reduce its reliance on antibiotics. By adding Bacillus subtilis to the chicken feed, the farm saw a marked reduction in gastrointestinal infections, and the flock’s overall health improved. As a result, the farm was able to phase out antibiotics entirely, leading to a more natural and eco-friendly farming system.
Conclusion: The Future of Probiotics in Poultry Farming

The use of probiotics in poultry farming is not just a passing trend; it’s a revolutionary approach that promises to transform the industry. With benefits like improved gut health, better feed efficiency, enhanced immunity, and higher-quality poultry products, probiotics are a game changer for sustainable agriculture.
Jaiguru Kadam’s insights and case studies demonstrate the real-world impact that probiotics can have on poultry farming, making it clear that probiotics are an essential tool for farmers seeking to boost both productivity and sustainability. As the poultry industry continues to embrace green innovation, probiotics will undoubtedly play a pivotal role in shaping the future of farming.
Are you ready to integrate probiotics into your poultry farm for healthier birds and higher-quality products? Reach out to explore how these strains can benefit your farm today!











